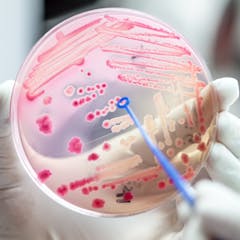

RCSI University of Medicine and Health Sciences

RCSI University of Medicine and Health Sciences is ranked first in the world for our contribution to UN Sustainable Development Goal 3, Good Health and Well-being, in the Times Higher Education (THE) University Impact Rankings 2023.
Founded in 1784 as the Royal College of Surgeons in Ireland (RCSI) with national responsibility for training surgeons in Ireland, today RCSI is an innovative, world-leading international health sciences university and research institution offering education and training at undergraduate, postgraduate and professional level.
Exclusively focused on education and research to drive improvements in human health worldwide, we are among the top 250 universities in the World University Rankings (2023) and have been awarded Athena Swan Bronze accreditation for positive gender practice in higher education.
Our expert researchers and clinicians recognise the responsibility to share their knowledge and discoveries with the public, empowering people with information that leads them to better health. With an emphasis on clinical and patient-centred research, our university collaborates with national and international researchers, institutions and industry partners to drive impactful discoveries.
Links
Displaying 1 - 20 of 67 articles